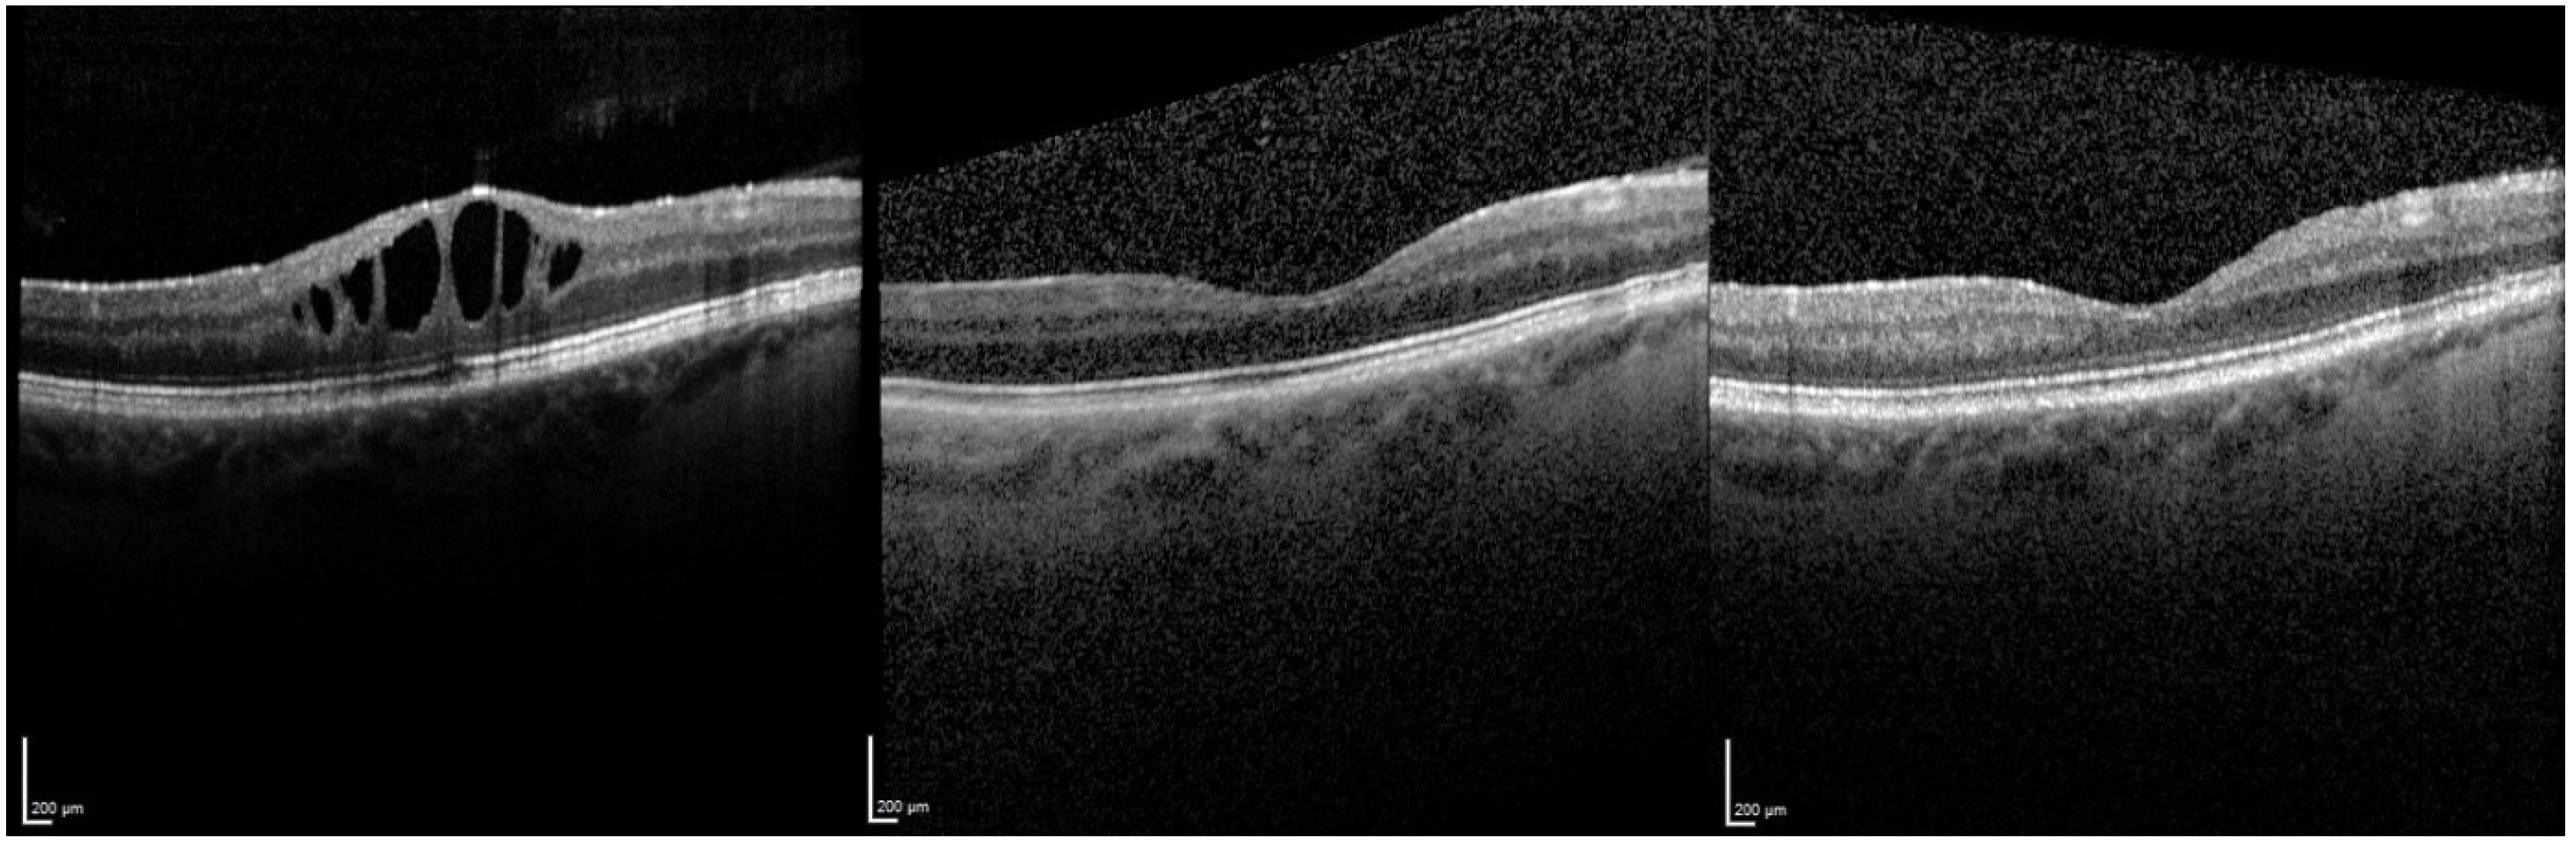
Jcm 10 03966 g003

Intravitreal 0.19 mg Fluocinolone Acetonide Implant in Non-Infectious Uveitis
Abstract
:1. Introduction
2. Methods
3. Results
3.1. Central Retinal Thickness (CRT)
3.1.1. Overall Effect of FAc Therapy
3.1.2. Relapse and Retreatment with a FAc Implant
3.1.3. Therapy Failures
3.2. Visual Acuity (VA)
3.2.1. Overall Effect of FAc Therapy
3.2.2. Stable VA after FAc Therapy (n = 9)
3.2.3. Worsening of VA after FAc Therapy (n = 5)
3.3. Uveitis Activity
3.4. Systemic Therapy
3.5. Adverse Events
3.5.1. Intraocular Pressure
3.5.2. Cataract Formation
3.5.3. Retinal Detachment
3.5.4. Hypotonia
4. Discussion
Author Contributions
Funding
Institutional Review Board Statement
Informed Consent Statement
Data Availability Statement
Conflicts of Interest
Limitation
References
- Lardenoye, C.W.T.A.; van Kooij, B.; Rothova, A. Impact of macular edema on visual acuity in uveitis. Ophthalmology 2006, 113, 1446–1449. [Google Scholar] [CrossRef] [PubMed]
- Thurau, S.R. Cystoid macular edema in uveitis. Ophthalmologe 2005, 102, 485–490. [Google Scholar] [CrossRef] [PubMed]
- Jabs, D.A.; Rosenbaum, J.T. Guidelines for the use of immunosuppressive drugs in patients with ocular inflammatory disorders: Recommendations of an expert panel. Am. J. Ophthalmol. 2001, 131, 679. [Google Scholar] [CrossRef]
- Sen, H.N.; Vitale, S.; Gangaputra, S.S.; Nussenblatt, R.B.; Liesegang, T.L.; Levy-Clarke, G.A.; Rosenbaum, J.T.; Suhler, E.B.; Thorne, J.E.; Foster, C.S.; et al. Periocular corticosteroid injections in uveitis: Effects and complications. Ophthalmology 2014, 121, 2275–2286. [Google Scholar] [CrossRef] [PubMed] [Green Version]
- Lowder, C.; Belfort, R.; Lightman, S.; Foster, C.S.; Robinson, M.R.; Schiffman, R.M.; Li, X.-Y.; Cui, H.; Whitcup, S.M. Dexamethasone intravitreal implant for noninfectious intermediate or posterior uveitis. Arch. Ophthalmol. 2011, 129, 545–553. [Google Scholar] [CrossRef] [PubMed]
- Kempen, J.H.; Altaweel, M.M.; Drye, L.T.; Holbrook, J.T.; Jabs, D.A.; Sugar, E.A.; Thorne, J.E. Benefits of Systemic Anti-inflammatory Therapy versus Fluocinolone Acetonide Intraocular Implant for Intermediate Uveitis, Posterior Uveitis, and Panuveitis: Fifty-four-Month Results of the Multicenter Uveitis Steroid Treatment (MUST) Trial and Follow-up Study. Ophthalmology 2015, 122, 1967–1975. [Google Scholar] [CrossRef] [PubMed] [Green Version]
- Callanan, D.G.; Jaffe, G.J.; Martin, D.F.; Pearson, P.A.; Comstock, T.L. Treatment of posterior uveitis with a fluocinolone acetonide implant: Three-year clinical trial results. Arch. Ophthalmol. 2008, 126, 1191–1201. [Google Scholar] [CrossRef] [PubMed]
- Cabrera, M.; Yeh, S.; Albini, T.A. Sustained-release corticosteroid options. J. Ophthalmol. 2014, 2014, 164692. [Google Scholar] [CrossRef] [PubMed]
- Celik, N.; Khoramnia, R.; Auffarth, G.U.; Sel, S.; Mayer, C.S. Complications of dexamethasone implants: Risk factors, prevention, and clinical management. Int. J. Ophthalmol. 2020, 13, 1612–1620. [Google Scholar] [CrossRef] [PubMed]
- Campochiaro, P.A.; Brown, D.M.; Pearson, A.; Chen, S.; Boyer, D.; Ruiz-Moreno, J.; Garretson, B.; Gupta, A.; Hariprasad, S.M.; Bailey, C.; et al. Sustained delivery fluocinolone acetonide vitreous inserts provide benefit for at least 3 years in patients with diabetic macular edema. Ophthalmology 2012, 119, 2125–2132. [Google Scholar] [CrossRef] [PubMed]
- Augustin, A.J.; Bopp, S.; Fechner, M.; Holz, F.; Sandner, D.; Winkgen, A.-M.; Khoramnia, R.; Neuhann, T.; Warscher, M.; Spitzer, M.; et al. Three-year results from the Retro-IDEAL study: Real-world data from diabetic macular edema (DME) patients treated with ILUVIEN® (0.19 mg fluocinolone acetonide implant). Eur. J. Ophthalmol. 2020, 30, 382–391. [Google Scholar] [CrossRef] [PubMed] [Green Version]
- Weber, L.F.; Marx, S.; Auffarth, G.U.; Scheuerle, A.F.; Tandogan, T.; Mayer, C.; Khoramnia, R. Injectable 0.19-mg fluocinolone acetonide intravitreal implant for the treatment of non-infectious uveitic macular edema. J. Ophthalmic Inflamm. Infect. 2019, 9, 3. [Google Scholar] [CrossRef] [PubMed]
- Jaffe, G.J.; Pavesio, C.E. Effect of a Fluocinolone Acetonide Insert on Recurrence Rates in Noninfectious Intermediate, Posterior, or Panuveitis: Three-Year Results. Ophthalmology 2020, 127, 1395–1404. [Google Scholar] [CrossRef] [PubMed]
- Jabs, D.A.; Nussenblatt, R.B.; Rosenbaum, J.T. Standardization of uveitis nomenclature for reporting clinical data. Results of the First International Workshop. Am. J. Ophthalmol. 2005, 140, 509–516. [Google Scholar] [CrossRef] [PubMed]
- Adán, A.; Pelegrín, L.; Rey, A.; Llorenç, V.; Mesquida, M.; Molins, B.; Ríos, J.; Keller, J. Dexamethasone Intravitreal Implant for Treatment of Uveitic Persistent Cystoid Macular Edema in Vitrectomized Patients. Retina 2013, 33, 1435–1440. [Google Scholar] [CrossRef] [PubMed]
- Jaffe, G.J.; Martin, D.; Callanan, D.; Pearson, P.A.; Levy, B.; Comstock, T. Fluocinolone acetonide implant (Retisert) for noninfectious posterior uveitis: Thirty-four-week results of a multicenter randomized clinical study. Ophthalmology 2006, 113, 1020–1027. [Google Scholar] [CrossRef] [PubMed]
- Jaffe, G.J.; Lin, P.; Keenan, R.T.; Ashton, P.; Skalak, C.; Stinnett, S.S. Injectable Fluocinolone Acetonide Long-Acting Implant for Noninfectious Intermediate Uveitis, Posterior Uveitis, and Panuveitis: Two-Year Results. Ophthalmology 2016, 123, 1940–1948. [Google Scholar] [CrossRef] [PubMed]
- Bodaghi, B.; Nguyen, Q.D.; Jaffe, G.; Khoramnia, R.; Pavesio, C. Preventing relapse in non-infectious uveitis affecting the posterior segment of the eye—Evaluating the 0.2 μg/day fluocinolone acetonide intravitreal implant (ILUVIEN®). J. Ophthalmic Inflamm. Infect. 2020, 10, 32. [Google Scholar] [CrossRef] [PubMed]
- Pavesio, C.; Heinz, C. Non-infectious uveitis affecting the posterior segment treated with fluocinolone acetonide intravitreal implant: 3-year fellow eye analysis. Eye 2021, 1–7. [Google Scholar] [CrossRef]
- Campochiaro, P.A.; Nguyen, Q.D.; Hafiz, G.; Bloom, S.; Brown, D.M.; Busquets, M.; Ciulla, T.; Feiner, L.; Sabates, N.; Billman, K.; et al. Aqueous levels of fluocinolone acetonide after administration of fluocinolone acetonide inserts or fluocinolone acetonide implants. Ophthalmology 2013, 120, 583–587. [Google Scholar] [CrossRef] [PubMed]

| No. of participants, n | 26 |
| No. of treated eyes, n | 34 |
| No. of binocular injections | 8 |
| No. of re-injections | 3 |
| Age when first injected, years (%) | |
| <30 | 1 (3.8) |
| 30–50 | 6 (23.1) |
| 50–70 | 14 (53.8) |
| >70 | 5 (19.2) |
| Mean, years (SD) | 58 (15.5) |
| Gender, n (%) | |
| Female | 18 (69.2) |
| Male | 8 (30.8) |
| Study period post-FAc implantation | |
| Mean, weeks (range) | 18 (1–60) |
| Uveitis classification, n (%) | |
| Uveitis anterior with ME | 1 (2.9) |
| Uveitis intermedia with ME | 24 (70.6) |
| Uveitis posterior with ME | 6 (17.6) |
| Panuveitis with ME | 3 (8.8) |
| Aetiology of non-infectious uveitis (eyes), n (%) | |
| Idiopathic | 17 (50.0) |
| Sarcoidosis | 3 (8.8) |
| Multiple sclerosis | 5 (14.7) |
| Rheumatoid arthritis | 2 (5.9) |
| Acute zonal outer occult retinopathy (AZOOR) | 1 (2.9) |
| Multifocal chorioretinitis and panuveitis (MCP) | 2 (5.9) |
| Birdshot chorioretinopathy | 2 (5.9) |
| Ocular tuberculosis (non-infectious when treated) | 2 (5.9) |
| Lens status, n (%) | |
| Phakic | 4 (11.8) |
| Pseudophakic | 30 (88.2) |
| Duration of macular edema prior FAc implantation, n | |
| <3 years | 7 (20.6) |
| >3–5 years | 5 (14.7) |
| >5–10 years | 13 (38.2) |
| >10 years | 9 (26.5) |
| Mean, years (SD) | 6.9 (4.0) |
| Severity of macular edema, n (%) | |
| CST < 300 µm | 10 (29.4) |
| CST ≥ 300 µm | 24 (70.6) |
| Patients with local therapy for ME, n (%) | |
| Intravitreal triamcinolone | 5 (19.2) |
| Orbital floors steroids | 24 (92.3) |
| Intravitreal dexamethasone | 26 (100) |
| Surgically implanted fluocinolone acetonide 0.59 mg (off-label) | 1 (3.8) |
| Patients with systemic therapy, n (%) | |
| None | 12 (46.2) |
| Corticosteroid (CS) only | 4 (15.4) |
| CS and immunomodulatory therapy | 10 (38.5) |
| Eyes (n) | Injections (n) | Mean (n) | SD | |||||
|---|---|---|---|---|---|---|---|---|
| pre FAc | post FAc | pre FAc | post FAc | pre FAc | post FAc | pre FAc | post FAc | |
| Dexamethasone intravitreal | 33 | 4 | 232 | 9 | 7 | 2.3 | 4.8 | 1.9 |
| Triamcinolone periocular | 30 | 3 | 84 | 6 | 2.8 | 2 | 1.7 | 1.7 |
| Triamcinolone intravitreal | 8 | 0 | 28 | 0 | 3.5 | 3.1 | ||
| Triamcinolone subconjunctival | 8 | 3 | 19 | 10 | 2.4 | 3.3 | 1.2 | 2.3 |
| Pre FAc | Post FAc | |||
|---|---|---|---|---|
| Systemic Treatment | n | Mean Dose | n | Mean Dose |
| Azathioprine | 1 | 50 mg/d | 1 | 50 m/d |
| Rituximab | 1 | 1000 mg/a | 1 | 1000 mg/a |
| Adalimumab | 1 | 40 mg/2w | 0 | 0 |
| Ciclosporin | 3 | 113 mg/d | 2 | 100 mg/d |
| Mycophenolate | 3 | 1080 mg/d | 2 | 360 mg/d |
| Methotrexate | 4 | 19 mg/w | 1 | 10 mg/w |
| Prednisolone | 6 | 13 mg/d | 6 | 5 mg/d |
| IOP Change after FAc Implantation, n (%) | |
|---|---|
| IOP increase > 5 mmHg | 7 (20.6) |
| IOP increase > 10 mmHg | 2 (5.9) |
| IOP increase > 20 mmHg | 0 (0) |
| Mean IOP increase, mmHg (SD) | 4.4 (3.7) |
| IOP lowering eyedrops | |
| Number of eyes (n) | 3 (8.8) |
| Number of eye drops, total | 5 |
| IOP lowering surgery Number of eyes (n) | 0 (0) |
Publisher’s Note: MDPI stays neutral with regard to jurisdictional claims in published maps and institutional affiliations. |
© 2021 by the authors. Licensee MDPI, Basel, Switzerland. This article is an open access article distributed under the terms and conditions of the Creative Commons Attribution (CC BY) license (https://creativecommons.org/licenses/by/4.0/).
Share and Cite
Hikal, M.; Celik, N.; Auffarth, G.U.; Kessler, L.J.; Mayer, C.S.; Khoramnia, R. Intravitreal 0.19 mg Fluocinolone Acetonide Implant in Non-Infectious Uveitis. J. Clin. Med. 2021, 10, 3966. https://doi.org/10.3390/jcm10173966
Hikal M, Celik N, Auffarth GU, Kessler LJ, Mayer CS, Khoramnia R. Intravitreal 0.19 mg Fluocinolone Acetonide Implant in Non-Infectious Uveitis. Journal of Clinical Medicine. 2021; 10(17):3966. https://doi.org/10.3390/jcm10173966
Chicago/Turabian StyleHikal, Muaas, Nil Celik, Gerd Uwe Auffarth, Lucy Joanne Kessler, Christian Steffen Mayer, and Ramin Khoramnia. 2021. "Intravitreal 0.19 mg Fluocinolone Acetonide Implant in Non-Infectious Uveitis" Journal of Clinical Medicine 10, no. 17: 3966. https://doi.org/10.3390/jcm10173966
APA StyleHikal, M., Celik, N., Auffarth, G. U., Kessler, L. J., Mayer, C. S., & Khoramnia, R. (2021). Intravitreal 0.19 mg Fluocinolone Acetonide Implant in Non-Infectious Uveitis. Journal of Clinical Medicine, 10(17), 3966. https://doi.org/10.3390/jcm10173966

